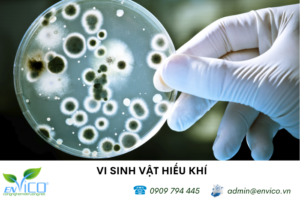
ung dung vi sinh vat hieu khi trong xu ly nuoc thai 1

Lưu trữ danh mục: Tin tức chuyên nghành
Bể kỵ khí là gì? Vai trò của chúng trong xử lý nước thải
Giải pháp xử lý nước thải hiệu quả và thân thiện với môi trường, bể [...]
Xử lý khí thải bằng phương pháp hấp thụ
Trong vô vàn giải pháp xử lý khí thải, phương pháp hấp thụ nổi lên [...]
Môi trường sống của sinh vật tác động đến xử lý nước thải
Bạn có bao giờ thắc mắc về thế giới sinh vật ẩn náu trong dòng [...]
Vi sinh vật hiếu khí là gì? Ứng dụng trong xử lý nước thải
Nước thải ngày càng trở thành vấn đề nhức nhối, ảnh hưởng nghiêm trọng đến [...]
Các biện pháp giảm thiểu ô nhiễm môi trường biển
Bạn có biết rằng, mỗi năm, có hơn 8 triệu tấn rác thải nhựa đổ [...]
Ô nhiễm chất thải rắn là gì: Nguyên nhân, Giải pháp
Bạn có từng lo lắng về rác thải sinh hoạt mỗi ngày gia đình bạn [...]
Top 5 công nghệ xử lý nước thải hiệu quả tiên tiến nhất hiện nay
Công nghệ xử lý nước thải là những giải pháp giúp loại bỏ các tác [...]
Công nghệ xử lý nước cấp hiệu quả nhất hiện nay
Công nghệ xử lý nước cấp là quá trình loại bỏ các chất độc hại [...]
TOP 6 Công nghệ xử lý khí thải hiệu quả, phổ biến nhất hiện nay
Các ứng dụng của công nghệ xử lý khí thải không chỉ giúp cải thiện [...]
Bể lọc sinh học là gì? Tất tần tật về các loại bể lọc sinh học
Bể lọc sinh học là một hệ thống xử lý nước thải sử dụng các [...]
Phương pháp hấp phụ xử lý nước thải và khí thải
Phương pháp hấp phụ là một quá trình mà một chất hoặc một chất khí [...]
Ứng dụng của nước vôi trong trong xử lý nước thải
Nước thải là một vấn đề nhức nhối của xã hội hiện đại, đang ngày [...]
Cách Làm Bể Lọc Nước Giếng Khoan Tại Nhà Đơn Giản – Hiệu Quả
Bể lọc nước giếng khoan là giải pháp tối ưu để xử lý nước nhiễm [...]
Top 10 kim loại nặng nhất hiện nay
Top 10 kim loại nặng nhất hiện nay bao gồm Osmi, Iridium, Bạch kim, Plutonium, [...]
TDS là gì? Chỉ số TDS trong nước nên bao nhiêu là đủ?
TDS là gì? TDS là một chỉ số đo lường lượng các chất rắn (vô [...]